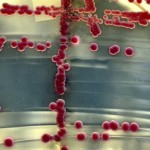

Cafeaua este nu numai energizantă şi călduroasă, dar, de asemenea, poate fi extrem de folositoare pentru voi.Pe parcursul multor ani şi decenii, oamenii de ştiinţă au studiat efectele cafelei asupra diverselor aspecte ale sănătăţii, şi rezultatele lor au fost puţin spus uimitoare.Aici sunt 10 din beneficiile cafelei, pentru care ea ar putea fi una dintre cele mai … [Read more...]
Descoperiri şi curiozităţi ştiinţifice
Descoperiri ştiinţifice importante. Ultimele cercetari şi descoperiri în fizică, medicină, astronomie, cosmologie ş.a.
Rezistenţă la antibiotice: Lumea este în pragul „erei post-antibiotice”
Lumea este în pragul "erei post-antibiotice", oamenii de ştiinţă au averitzat despre găsirea unei bacterii rezistente la toate medicamentele utilizate atunci când toate celelalte tratamente au eşuat.Ei au identificat bacteria care ignoră cel mai puternic medicament de ultimă oră, colistin-ul, la pacienţii şi animalele din China.Ei au spus că rezistenţa se va extinde în … [Read more...]
Calculatoarele cuantice la un pas mai aproape după descoperirea australiană
Inginerii de la Universitatea din Noul Wales de Sud, Australia, au făcut un progres important care aduce calculatoarele cuantice la un pas mai aproape de realitate.Echipa a creat o versiune cuantică a unui cod de computer standart într-un cip de siliciu. Descoperirea arată că este posibilă construirea unor computere cuantice realiste şi sigure.Calculatoarele cuantice au … [Read more...]
Oamenii de ştiinţă pentru prima dată au urmărit formarea unei planete
Pentru prima dată oamenii de ştiinţă au urmărit formarea unei planete şi au făcut poze a particulelor de praf şi gaz care se acumulează împreună pentru a creea o protoplanetă într-un sistem solar îndepărtat.Vedeţi şi: 20 de curiozităţi despre univers şi informaţii interesanteCercetătorii din SUA şi Australia au observat fenomenul care are loc în sistemul solar din jurul … [Read more...]
Eliminarea anumitor gene ar putea creşte durata vieţii cu 60 la sută
Oamenii de ştiinţă au descoperit mai mult de 200 de gene legate de îmbătrânire şi consideră că eliminarea lor poate duce la prelungirea vieţii.Secretul prelungirii vieţii cu zeci de ani poate consta în întreruperea activităţii anumitor gene, cred oamenii de ştiinţă, după ce au arătat că mici trucuri genetice pot face unele organisme să trăiască cu 60 la sută mai … [Read more...]
15 realizări incredibile din lumea musulmană în Epoca de Aur a Islamului
În ciuda faptului că nu există aşa termen înrădăcinat ca ştiinţă islamică - trebuie însă să recunoaştem faptul că în perioada Evului Mediu întunecat din Europa, progrese ştiinţifice incredibile s-au făcut anume în lumea musulmană.Odată cu invadarea triburilor nomade, destrămarea Imperiului Roman, Europa occidentală a intrat în declin, marcând scăderi după diverşi indicatori … [Read more...]
Homo naledi: a fost descoperită o nouă specie umană preistorică
Oasele găsite în peştera din Africa de Sud aparţin, susţin cei care le-au descoperit, unei specii preistorice noi înrudită cu cea umană, Homo naledi, deşi unii experţi sunt sceptici ce priveşte desoperirea.O mulţime de oase au fost găsite într-o cameră mică întunecată în spatele unei peşteri din Africa de Sud, care pot fi rămăşiţele unei specii umane noi înrudite cu … [Read more...]
10 lucruri care trebuie să le ştiţi despre găurile negre
Lucruri interesante despre găurile negre şi ceea ce le face mai mult sau mai puţin deosebite de orice altceva în Univers. 1. Ce este o gaură neagră? Proprietatea principală care definește o gaură neagră este orizontul său, care este granița unei regiuni din care nimic, nici măcar lumina, nu poate scăpa.Dacă regiunea rămâne deconectată pentru totdeauna, vorbim de un orizont de … [Read more...]
Nava spaţială New Horizons va şuiera pe lângă Pluton
Pluton este gata să apară în prim plan. La 14 iulie, nava spaţială New Horizons va zbura pe lângă Pluton. Obiectul îndepărtat a fost retrogradat de la o planetă la o planetă pitică în 2006, dar acest fapt nu diminuat din strălucirea misiunii care marchează începutul unei noi frontiere de explorare.După ce a călătorit nouă ani aproape 5 miliarde de kilometri prin … [Read more...]
Omul vechi găsit în Romania are 10 procente gene de la Neanderthal
ADN-ul unui om care a trăit în urmă cu 40 de mii de ani în România, arată că până la 11 procente din genomul lui a venit de la neanderthalieni.Deoarece segmente mari de cromozomi individuali sunt de origine de la Neanderthal, reese că un Neanderthal a fost prin strămoşii omului găsit nu mai târziu de patru generaţii în urmă în arborele familiei sale, raportează un studiu … [Read more...]
- « Previous Page
- 1
- …
- 20
- 21
- 22
- 23
- 24
- …
- 26
- Next Page »